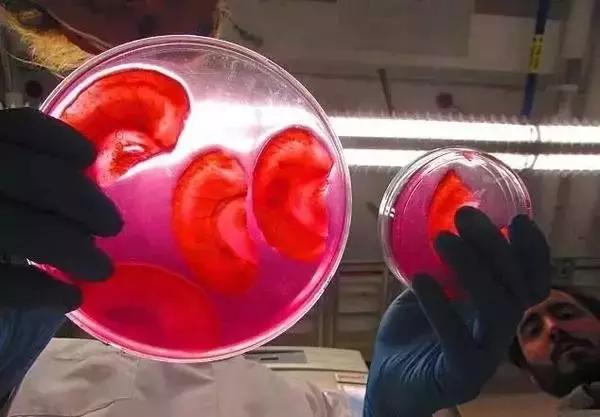
这位生物黑客教授竟然从苹果中培育出耳朵，功能与常人无异

猜猜下面图片中大叔手里拿的培养皿里装的东西是什么?可能你第一直觉印象是人的耳朵,不过如果我告诉你,这是用苹果培育出来的人耳朵,你是不是觉得很神奇呢
这里不是拍摄惊悚片的现场,而是渥太华大学教授德鲁·佩林的培育实验室,这位有“生物黑客”之称的教授在这个实验室里玩出了医学黑科技,用苹果培育出了耳朵。
佩林先生的工作就是在大家生活中常见的甚至认为是垃圾的东西中寻宝。他喜欢到处游玩,他说这是训练自己的思维保持非常规的方式。

安德鲁·佩林小时候就喜欢将玩具拆开了又拼装起来,喜欢用用零件拼装出新奇的玩具。长达以后,他这种“拆了再装”的爱好没有改变,还应用到医学上,成功用植物培育出*体器人官**。

“这不是一件令人毛骨悚然的事情” 佩林在最近的演讲中说,我通常只是在寻找旧的电子产品,并且带到我的实验室。实验室的最新项目之一是从苹果细胞中提取“人类耳朵”。

这个想法源于他与成员奥德丽的一次对话,在谈到恐怖的音乐商店的巨型怪兽时,他想知道能否在实验室里也培育出个“怪物”。
实验最开始是想用纤维素骨架使植物去除其细胞结构,但在剥叶蜡质层时遇到了麻烦。有一天,佩林发现另一个实验室成员正在吃一个苹果,他决定用苹果代替。

说干就干,佩林直接带着团队开始了新的实验:先把苹果切成小片,然后用开水和洗涤剂除去苹果上所有的植物活体细胞和 DNA,只留下保持苹果形状和口感的纤维素骨架。
最后在只剩下纤维素骨架的苹果上植入人类的细胞,让细胞在骨架上繁育,慢慢地人类的细胞就会充满整个骨架的空隙。这些人体细胞可以被视为下面图像中的蓝色部分,通过扫描电子显微镜拍摄,染色显示人类细胞。
当然,种出了细胞组织还不算完,毕竟没有谁的耳朵长成一个苹果的形状。为了让这些“人肉苹果”更“好看”,安德鲁·佩林让擅长雕刻的妻子帮忙将苹果片雕成了人耳的形状,然后再进行种植,等细胞种上之后,就会自动“长成”耳朵的形状。
更为逆天的是,在实验的过程中,佩林发现,这种“人耳苹果”不仅外表与人耳无异,在移植到人体后还可以正常工作,身体会自动提供细胞和血液来维持其生命活动。
这个项目的意义在于用比较便宜的苹果与其他方法就建造出身体部分支架。
佩林说:“商业支架确实很昂贵,而且有问题,因为它们来源于专利产品、动物或尸体。”我们用了一个苹果,只花了九便士。

佩林成立了一个由任务驱动的公司,开发出成套工具,让那些有水槽和烙铁的人更容易在家里生产这些东西。

这些支架技术开放了源代码,可以在线指导。该技术尚未出售,但预售信息可以在公司网站上找到。
从病人自己的干细胞中培育出器官,将有助于解决世界范围的*体器人官**短缺问题。科学家们正在研制一种专门的干细胞,这种细胞可以被移植到支架上,成为肝脏、心脏或皮肤。

这个实验室还在研究其他的产品,比如芦笋,可以帮助修复脊髓损伤。切开的芦笋中有许多纤维素组成的细小导管,这些和人类的血管、神经和脊髓的结构非常相似;玫瑰花瓣的纤维素结构又薄又平整,做皮肤挺合适……

这些和人类的血管神经和脊髓的结构非常相似


玫瑰花瓣的纤维素结构又薄又平整,做皮肤挺合适
